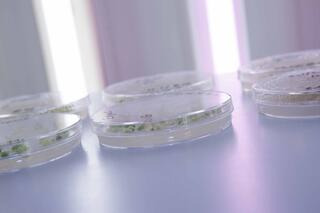

-
 Mikrosporen unter dem Mikroskop
Mikrosporen unter dem Mikroskop -
Verfeinerung der Methoden
Verfeinerung der Methoden -
 Pflanzenentwicklung aus Kallus
Pflanzenentwicklung aus Kallus -
 Pflanzen aus Embryo Rescue
Pflanzen aus Embryo Rescue

Analyseergebnis
Forschungsprojekte
Resistenz gegen Krankheitserreger, z.B. bei Getreide, ist eine Grundvoraussetzung für die Produktion sicherer und gesunder Lebensmittel. Ein Teil unserer Projekte wird mit dem Ziel geplant, neue und potenziell dauerhafte Resistenzen gegen die wichtigsten pilzlichen, viralen und tierischen Schaderreger zu erforschen.
Saaten-Union Biotec pflegt vielfältige Kontakte zu internationalen privaten und öffentlichen Forschungseinrichtungen und beteiligt sich aktiv an Verbundforschungs- und Entwicklungsprojekten.
Wir optimieren ständig Protokolle und Verfahren nach den neuesten Erkenntnissen. Somit sind wir führend auf vielen Gebieten.






